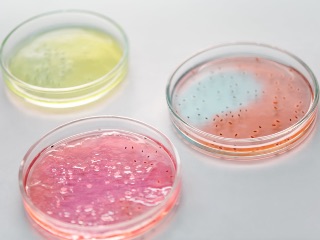
Ancient Microbes May Help in Search for Life on Other Planets, Claims New Study

- Home
- Science
- Science News
- Scientists Discover Year Round Ozone Hole Over Tropics, May Lead to Increased Ground Level UV Radiation
Scientists Discover Year-Round Ozone Hole Over Tropics, May Lead to Increased Ground-Level UV Radiation
The tropics constitute half the planet's surface area and are home to about half the world's population, and the existence of the ozone hole may cause global concern.

Photo Credit: Pixabay/ TheDigitalArtist
Depletion of the ozone layer can lead to increased ground-level UV radiation
Scientists revealed a large, all-season ozone hole in the lower stratosphere over the tropics comparable in depth to that of the well-known springtime Antarctic hole, but roughly seven times greater in area. The observed data agree well with the cosmic-ray-driven electron reaction (CRE) model and strongly indicate the identical physical mechanism working for both Antarctic and tropical ozone holes.
In AIP Advances, by AIP Publishing, Qing-Bin Lu, a scientist from the University of Waterloo in Ontario, Canada, reveals a large, all-season ozone hole — defined as an area of ozone loss larger than 25 percent compared with the undisturbed atmosphere — in the lower stratosphere over the tropics comparable in depth to that of the well-known springtime Antarctic hole, but its area is roughly seven times greater.
"The tropics constitute half the planet's surface area and are home to about half the world's population," said Lu. "The existence of the tropical ozone hole may cause great global concern.
"The depletion of the ozone layer can lead to increased ground-level UV radiation, which can increase risk of skin cancer and cataracts in humans, as well as weaken human immune systems, decrease agricultural productivity, and negatively affect sensitive aquatic organisms and ecosystems."
Lu's observation of the ozone hole comes as a surprise to his peers in the scientific community, since it was not predicted by conventional photochemical models. His observed data agree well with the cosmic-ray-driven electron reaction (CRE) model and strongly indicate the identical physical mechanism working for both Antarctic and tropical ozone holes.
As with the polar ozone hole, approximately 80 percent of the normal ozone value is found to be depleted at the centre of the tropical ozone hole. Preliminary reports show ozone depletion levels over equatorial regions are already endangering large populations and the associated UV radiation reaching these regions is far greater than expected.
In the mid-1970s, atmospheric research suggested the ozone layer, which absorbs most of the sun's ultraviolet radiation, might be depleted because of industrial chemicals, primarily chlorofluorocarbons (CFCs). The 1985 discovery of the Antarctic ozone hole confirmed CFC-caused ozone depletion. Although bans on such chemicals have helped slow ozone depletion, evidence suggests ozone depletion persisted.
Lu said the tropical and polar ozone holes play a major role in cooling and regulating stratospheric temperatures, mirroring the formation of three "temperature holes" in the global stratosphere. He said this finding may prove crucial to better understanding global climate change.
Lu's discovery builds on previous studies of the CRE-initiated ozone-depleting mechanism that he and his colleagues originally proposed about two decades ago.
"The present discovery calls for further careful studies of ozone depletion, UV radiation change, increased cancer risks, and other negative effects on health and ecosystems in the tropical regions," said Lu.
Get your daily dose of tech news, reviews, and insights, in under 80 characters on Gadgets 360 Turbo. Connect with fellow tech lovers on our Forum. Follow us on X, Facebook, WhatsApp, Threads and Google News for instant updates. Catch all the action on our YouTube channel.
Related Stories
- Samsung Galaxy S26 Ultra
- Motorola Razr Fold
- ChatGPT
- OPPO Find N6
- Mobiles Under Rs. 40,000
- Vivo X300 Ultra
- Asus Zenbook S14
- iQOO 15
- Vivo X300 Pro
- Lenovo Yoga Slim 7i Aura Edition
- iQOO 15R
- Vivo X Fold 5
- Sony PlayStation 5
- HP OmniPad 12
- OnePlus Nord CE 6 Lite
- OnePlus Pad 4
- OPPO F33 Pro 5G
- Cryptocurrency
- HP OmniBook Ultra 14 (2026)
- iPhone 17
- Eureka Forbes AP 355 Room Air Purifier
- Latest Mobile Phones
- Compare Phones
- Vivo Y600 Turbo
- Realme 16T 5G
- Xiaomi 17 Max
- HMD Vibe 2 5G
- iQOO 15T
- Lenovo Legion Y70 (2026)
- Red Magic 11S Pro+
- Red Magic 11S Pro
- Microsoft Surface for Business (2026, 15-Inch)
- Microsoft Surface for Business (2026, 13.8-Inch)
- Poco Pad C1
- iQOO Pad 6 Pro
- Realme Watch S5
- Xiaomi Smart Band 10 Pro
- Lumio Vision 9 (2026)
- Lumio Vision 7 (2026)
- Asus ROG Ally
- Nintendo Switch Lite
- IFB 1.5 Ton 3 Star Inverter Split AC (CI193GN22RGM3)
- IFB 2 Ton 3 Star Inverter Split AC (CI223GD32RGM3)